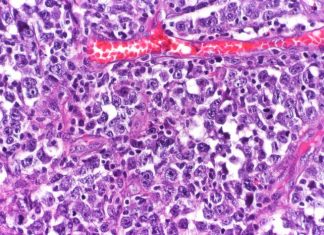
New research reveals cause, potential precision therapies for aggressive type of lymphoma New research reveals cause, potential precision therapies for aggressive type of lymphoma

New research finds gut bacteria can make blood pressure medication less...
A new study from The University of Toledo College of Medicine and Life Sciences has shown gut bacteria can reduce the effectiveness of certain...
Avoid late afternoon, evening coffee reports new study
Coffee is a common morning beverage; however, some indulge in a late afternoon cup for a pick-me-up, or cap off their dinner with a...
New research reveals cause, potential precision therapies for aggressive type of...
DNA mutations are essential to the rapid development of an array of antibody-producing immune cells called B cells that collectively can recognize a vast...
Is the Hygiene Therapy Hypothesis for Autism Treatments Psuedoscience?
Is the hygiene hypothesis for Autism treatments pseudoscience? It really is hard to say, but many people may see this as gross if not...
Stem cell cloning scientists unraveling cystic fibrosis
Two nationally recognized experts in cloning and stem cell science from the University of Houston are taking the first step toward limiting the consequences...
The acceptability of stress makes us fat and sick
The flight or fight response refers to the body's physiological responses to outside threats. In high stress reactions, the body conserves functional energy in...
Study: Genetic test can diagnose certain immune system disorders
Primary immunodeficiency disorders (PID) can result in chronic and sometimes life-threatening infections. More than 450 PIDs have been described, but timely and accurate diagnoses...
Mercury in sushi poses significant health risks
Effects of high mercury exposure include neurodevelopmental deficits, poor cognition and heart disease
Fish contains omega-3 (n-3) fatty acids that reduce cholesterol levels, reduce risk...
New study sheds light on crimean-congo hemorrhagic fever disease process
Army scientists determined that the body’s own natural immune response contributes to disease severity in mice infected with Crimean-Congo hemorrhagic fever virus (CCHFV), which...
How to handle stress caused by real-life issues
Dr. Steven Haymon is an expert in helping people across the country cope with the stresses of real-life issues as a practicing psychotherapist, consultant...